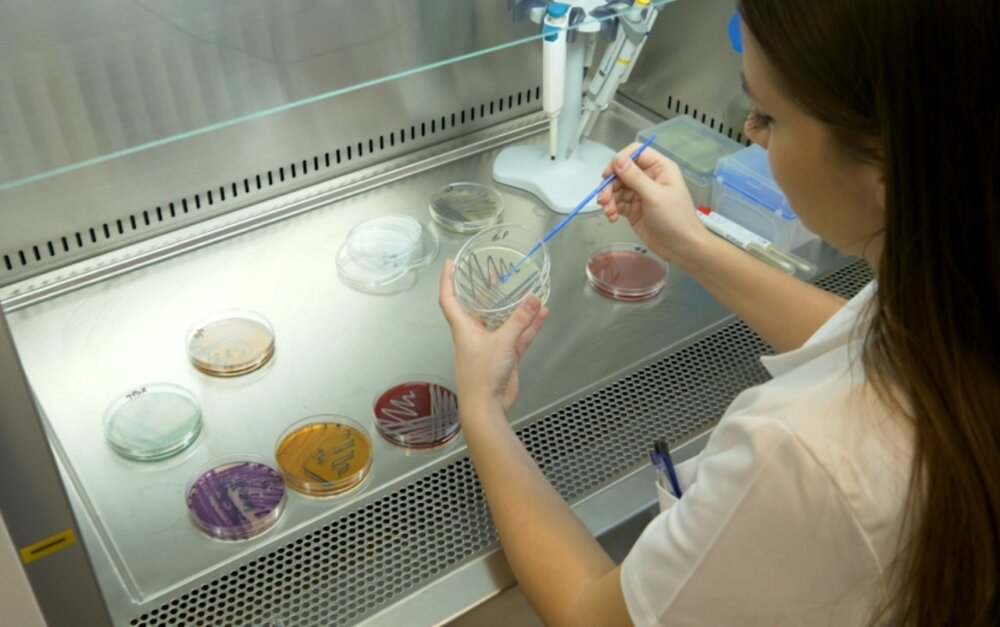
INTERVJU Olja Šovljanski, najbolja mlada naučnica u Srbiji: Kad im damo šansu, mikroorganizmi će pomiriti čoveka i prirodu 3

Foto: Privatna arhiva
Foto: Privatna arhivaOlja Šovljanski iz Novog Sada najbolja je mlada naučnica u Srbiji, dobitnica prеstižnog priznanja – Danubius Young Scientist Award za najboljеg istraživača iz naše zemlje za 2023. godinu. Bavi se oblastima tehnološke mikrobiologije i naučna je saradnica na Katedri za biotehnologiju novosadskog Tehnološkog fakulteta.
Rođena je Novosađanka kaže već punih 30 godina i majka jedne divne devojčice Lenke. „Izbegla“ je iz porodice novinara u svet prirodnih nauka i nikada se nije pokajala zbog toga.
Sebe opisuje i kao „večitog Šerlok Holmsa, zaljubljenika u hranu i borca za pravdu“.
Nakon srednje medicinske škole, upisala je Tehnološki fakultet, smer Biohemijsko inženjerstvo kao jedne od najperspektivnijih grana za unapređenje modernog društva.
„Bio je to spoj prirodnih nauka na nekom novom nivou, koji sam zaista lako savladala i nastavila taj put i na master studijama. Već u drugoj godini osnovnih studija sam imala priliku da radim studenski istraživački rad u Laboratoriji za mikrobiologiju i tu pokazala da sam i manuelno spretna i da ću možda od toga zarađivati i živeti. Pošto mi nije bilo dosta školovanja, upisala sam i doktorske studije na studijskom programu Biotehnologija i u roku od četiri godine stekla titulu doktora nauka – tehnološko inženjerstvo“, kaže Šovljanski.
Upisom na doktorat počeo je i njen naučnoistraživački rad i karijera u oblasti tehnološke mikrobiologije. Na svoju ruku i zbog sklonosti ka drugim sferama mikrobiologije, usput je završila i specijalističke studije Mikrobiološka bezbednost hrane. Tako je dodaje, skupila sve one prefikse i skraćenice pored imena kojima se sujetni ljudi hvale, a njoj su omogućili da napreduje u naučnim oblastima prehrambene biotehnologije i biotehnologije u građevinskom inženjerstvu.
– Nagrade uvek prijaju, pogotovo mladim naučnicima, a vi ste ih već dobili mnogo?
Svaka nagrada je specifična i došla je u nekom skladnom trenutku za moja istraživanja, ali mislim da mi je posebno drago Specijalno priznanje Fondacije Docent dr Milena Dalmacija koje se dodeljuje za doktorske disertacije koje su imale najveći doprinos u oblasti zaštite životne sredine. Posebnost ove nagrade ne ogleda se samo kroz Fondaciju koja je dodeljuje, već i zbog činjenice da je doktorska disertacija rađena eksperimentalno u najvećem talasu COVID-19 pandemije. Ubrzo je usledela i druga Nagrada za najbolje mlade naučnike i istraživače Fonda Dr Zoran Đinđić. Ona se izdvaja po gorkom ukusu koji je ostao nakon odbrane prezentacije kandidata u užem krugu jer je tad izašlo na videlo zašto je Pravilnik o nagrađivanju promenjen preko noći, kao i da se ne smatra sukobom interesa da nagrađeni bude istraživač člana Komisije za dodelu nagrada. Najznačajnija nagrada za sve buduće naučne izazove svakako jeste evropska nagrada za najbolje mlade istraživače Danubius Young Scientist Award 2023. Kao neko ko je rastao pored Dunava, smatram da je ova nagrada za stvaralaštvo i naučnu izuzetnost za istraživanja vezana za Dunavski region i lična, a ne samo profesionalna satisfakcija. Meni je data šansa da uradim nešto za taj naš Dunav, za tu našu ravnicu, za tu našu decu, i zato smatram da je svaki vid izdvajanje iz mase veoma bitan i treba da bude promovisan i van naših granica. Ta nagrada nije nagrada pojedinca, već i tima koju mlad naučnik predstavlja.

– U doktorskoj disertaciji bavili ste se bakterijskim izolatima iz reke Dunav koji imaju značajan biokalcifikujući potencijal. Kako ste se uopšte zainteresovali za ovu temu?
Doktorska istraživanja su obuhvatila priču o pet bakterija izolovanih iz vode, mulja i sedimenata reke Dunav. Ove bakterije, koje ne predstavljaju opasnost za čoveka, mogu da vrše proces koji se stručno naziva mikrobiološki indukovana precipitacija karbonata. Uprošćeno govoreći, ove bakterije izuzetno efikasno stvaraju karbonate, a nadalje u prirodnim ili inženjerski konstruisanim procesima, predstavljaju pokretače hemijskih reakcija. Taj niz događaja u kojima učestvuju ove bakterije na kraju dovodi do stvaranja kristala kalcijum karbonata koji se talože. Ovaj proces se normalno i u kontinuitetu dešava u prirodi kroz stvaranje sedimenata, stabilizaciju zemljišta, sprečavanje erozije, itd.
Međutim, jako malo broj bakterija je dovoljno efikasan da to rade u kratkom vremenskom periodu. Iz ugla inženjera, ono što nije komercijalno dostupno, a postoji u prirodi rađa ideju o mogućnosti primene i stvaranja novog proizvoda na tržištu. Pokazalo se da su upravo ove dunavske bakterije itekako efikasne i imaju pun potencijal da budu daleko više od „lokalaca“.
– Tako smo došli i do toga da bakterije mogu biti ključan sastojak nečega što nazivamo samolečivi beton. Kakve bi sve probleme on mogao da nam reši?
U poslednjim godinama pokrenula se priča da cementni materijali, pre svega beton, imaju mogućnost da se samoobnavljaju. To samolečenje je ustvari posledica postojanja nehidratisanih delova betona koji naknadno stupaju u hemijske reakcije i dolazi do stvaranja kristala kalcijum karbonata. Međutim taj efekat je spor i bilo je potrebno naći efikasne „pokretače“ koji će omogućiti isto to – stvaranje tih kristala, ali gotovo trenutno. Postoje brojne verzije i načini da se ovo pokrene, ali je naša ideja bila da spojimo prirodno sa prirodnim na inženjerskom nivou. Ako postoji šansa da bakterija bude taj pokretač, onda se dobija biotehnološki, inovativni produkt tj. samoobnavljajući beton nove generacije koji je po svim ekološkim kriterijumima prihvatljiv. Njegova primenljivost se ogleda u činjenici da onog momenta kada nastane pukotina u betonskoj matrici, bakterije aktiviraju proces stvaranja kristala i popunjavaju pukotinu dok je još mala. Na ovaj način se sprečava širenje pukotine, potencijalna destrukcija betona i kolaps infrastrukturne ili stambene jedinice koja je napravljena od betona. Na taj način je rešena najveća mana betona kao građevinskog materijala (pojava pukotina) i produžen životni vek zgrade, mosta, tunela, bunara i sl. Ako se beton sam obnavlja na mikronivou, nema potrebe da se vrše popravke čime se smanjuje ljudska greška i troškovi za održavanje. Primena ovakvih materijala posebno je značajna kod formi čiji kolaps bi mogao da ugrozi zdravlje ljudi – betonski bunari za odlaganje infektivnog otpada, stubovi mostova, tuneli i slično, i sa tog aspekta je opravdano i veće startno ulaganje u ovakav beton.
– Koliko će novi materijali biti nužni za funkcionisanje ljudi u budućnosti?
Bezbednost materijala tj. sredine oko nas je ključna. Bilo to u prirodi gde bi se istraženi prirodni proces inženjerski unapredio i višestruko ubrzao, ili pak u pogledu sigurnosti u stambene zgrade, infrastrukturne jedinice, sisteme za odlaganje otpada. To je svakodnevno pitanje koje nas nesvesno okružuje i setimo ga se tek kad dođe do nekog loše scenarija. Ne mora to biti neka ljudska greška, dovoljno je napomenuti da niko ne može da nas zaštiti od zemljotresa ili erozije tla. Međutim, formiranjem biotehnoloških rešenja postoji značajna mogućnost da se poboljšaju materijali, osiguraju bolja mehanička svojsta i stabilnost materijala, produži garancija životnog veka materija. To je kategorija na kojoj ne smemo da štedimo i koja mora biti stub razvoja, čak i u nerazvijenim zemljama. Upravo ta bezbednost koju nude napredni biotehnološki sistemi je ključna za normalno funkcionisanje ljudi u budućnosti.
– Kako bi trebalo da izgledaju ti multifunkcionalni materijali budućnosti?
Jednostavni, samoodrživi, laki za upotrebu, da ne zahtevaju specifičan trud i rad, i dodatno, ako je moguće, imaju način da nas na vreme upozore na promene koje nadolaze. Neki bi rekli da će nas takvi materijali zaglupeti, međutim primena istih je usmerena tamo gde je i ljudska greška do sada bila najveća ili tamo gde je opasnost bila nevidljiva. Izdvojila bih nekoliko primera, a pre svega primenu tzv. veštačke kože za teške povrede ovog organa kod ljudi koje mogu da izazovu smrtni ishod, ali i veliki funkcionalni i estetski problem. Ovaj kompozit je samoobnavljajući, potpuno kompatibilan sa našom kožom i kada se nanese na povređeno tkivo, srasta sa njim i kontrolisano otpušta bioničke mikrovaskulatne agense koji omogućavaju prihvatanje stranog tela i pokrivanje povređenih delova.
Sa druge strane, veoma popularne su samoobnavljajuće presvlake za automobile koje mogu da zaleče ogrebotine za svega 30 minuta. One su prvenstveno napravljene za svemirske letelice, ali je ubrzo sagledano da mogu da se primene za prevozna sredstva, elektroniku i druge uređaje koje su izloženi mehaničkom habanju. I na kraju, nešto što je veoma realno da će uskoro biti prisutno i na tržištu zemalja trećeg sveta jeste multifuncionalna ambalaža koja sadrži antimikrobna sredstva i senzore koji omogućuju produženje roka upotrebe upakovane hrane, ali i signaliziraju da je došlo do kvarenja. Na taj način kupac neće doći u zabludu da kupi nešto i tek u svom domu ili nakon nastupanja trovanja shvati da je proizvod neprihvatljiv za konzumiranje.
– Vratimo se na mikroorganizme. Oni su se nekada samo umnožavali, a na koje sve načine se danas koriste u različitim biotehnološkim procesima?
Svako ko konzumira hleb, pivo, rakiju, jogurt, insulin, vitamine, probiotike ustvari je nesvesno (celoživotni) potrošač biotehnoloških dobara. Svi ovi tradicionalni proizvodi, ali i mnogi drugi poput vakcina i genskih terapija, upravo su proizvodi koji su mikrobiološkog porekla ili su nastali pomoću mikroorganizama. Nekada su se mikroorganizmi koristili primenom jednostavnih metoda umnožavanja ćelija, kao što se to radilo u kućnim uslovima kada se pravilo testo, jogurt, vino. Danas se to sve usložnilo, ne koriste se samo ćelije, već i ono što one produkuju (vitamini, pigmenti, kristali, polisaharidne matrice, itd), pa je formirana metodologija koja je prilagođena industrijskim sistemima, omogućava više procesa u jednom koraku, selektivnija je i bezbednija za čoveka. Napomenula bih da je oblast biotehnologije koja je zaokupljena oko prehrambene industrije, a posledično i naprednih materijala koji se primenjuju u ambalaži i pakovanju, predstavlja jednu od osnovnih strategija razvoja modernog i zdravog društva. Mi koji se bavimo ovom oblasti moramo širiti biotehnološku svest među širu javnost. Postoji toliko rešenja globalnih izazova upravo pomoću biotehnoloških alata, ali našem narodu su oni nevidljivi. Razlog tome je minimalna edukacija i usmerenost ka ovim tehnologijama u našoj zemlji, ali i neprepoznavanje bitnosti da reagujemo sada za budućnost naše dece.

– Na koje sve načine će nam bakterije pomagati u budućnosti? Ljudi u nekim svojim predrasudama često kažu da će nas „bakterije“ na kraju pobediti. Ali mogu li nam one pomoći da rešimo neke svoje krucijalne sadašnje probleme? Mogu li bakterije pomiriti čoveka i prirodu?
Moj stav je da se mikroorganizmima treba diviti, a da je rat protiv njih unapred izgubljena budućnost. Razlog ovome je činjenica da se, na primer, bakterija Escherichia coli, najčešće korišćene bakterije za istraživanja, razmnožava u roku od 20 minuta i novonastalim ćelijama prenosi svo svoje „iskustvo“ o funkcionisanju, opasnostima, načinima da preživi. Sa druge strane, čoveku treba u proseku 30 godina života da dobije potomka koji je u potpunosti nespreman za „spoljni“ svet i sve treba da uči iznova. I tako dođete do razmatranja da li smo mi ti koji smo svesni organizmi spremni za ovaj svet, ili su pak to bakterije koje su uspele da toliko puta evoluiraju i opstanu na našoj planeti. Ima još jedna zanimljiva činjenica o mikroorganizmima i ljudima. Dokazano je da na svaku ćeliju našeg organizma u na nama živi 10 ćelija mikroorganizama.
Oni su mahom smešteni u gastrointestinalnom traktu, gotovo svi su tu da nam pomognu da se složeni biohemijski ciklusi održe. Ćelijski gledano, to znači da smo mi samo 10 odsto ljudi, a ostatak smo putujuća mikrobna zajednica. Da li se protiv toga uopšte vredi boriti? Nažalost, ljudi veoma pogrešno gledaju na mikroorganizme. Samo 5 odsto poznatih mikroorganizama može da ugrozi zdravlje ljudi, a ostali su deo prirode i omogućavaju balans u prirodi. Nezgodno je to što su ljudi toliko zagađivači da mikrobiloška zajednica na Zemlji ne stiže da vrati ravnotežu dovoljno brzo. Kada im budemo dali šansu, tada mikroorganizmi mogu da pomire čoveka i prirodu.
– Koliko vam je važno što se sve ovo zanimljivo o čemu razgovaramo događa baš na Tehnološkom fakuletu?
Katedra za biotehnologiju ima visok nivo naučne izvrsnosti, kvaliteta i inovativnosti ideja predstavlja fundamentalnu vrednost ove Katedre kojoj pripadam od početka svog akademskog i profesionalnog života. Smatram da je veliko iskustvo u prenošenju znanja i veština na mlade istraživače bila pokretač mnogobrojnih naučnih ideja koje danas žive kroz mnogobrojne projekte pokrajinskog, nacionalnog i međunarodnog nivoa, omogućavaju privredni i ukupni društveni razvoj naše države i svakako su lepa slika uspešnosti mladog čoveka.
– Kako se snalazite u novoj ulozi u životu, niste u laboratoriji koliko ste navikli?
Trenutno su mi hobiji nespavanje i kontinuirana nabavka igračaka u nadi da će nešto biti zanimljivije od nameštaja, kvaka, frižidera i slično. Takođe, redovne šetnje sa bebom novonaseljskim ulicama su jedna od lepših uspomena tokom ovog odsustva iz naučnih dubina. Pre mnogo godina sam dobila savet od starog prijatelja da treba šetati uvek pravo dok može pa gde se pojavi zeleno na semoforu, tu skrenuti i ići dalje. Neverovatno je koliko mi je sad ta taktika donela anegdota, smeha i razmenjenih informacija. Sa druge strane, večita aktivnost kojoj se rado vraćam je putovanje, sa omiljenim čovekom uz dobru muziku, i isprobavanje lokalne hrane.
Više informacija iz ovog grada čitajte na posebnom linku.
Pratite nas na našoj Facebook i Instagram stranici, ali i na X nalogu. Pretplatite se na PDF izdanje lista Danas.
















